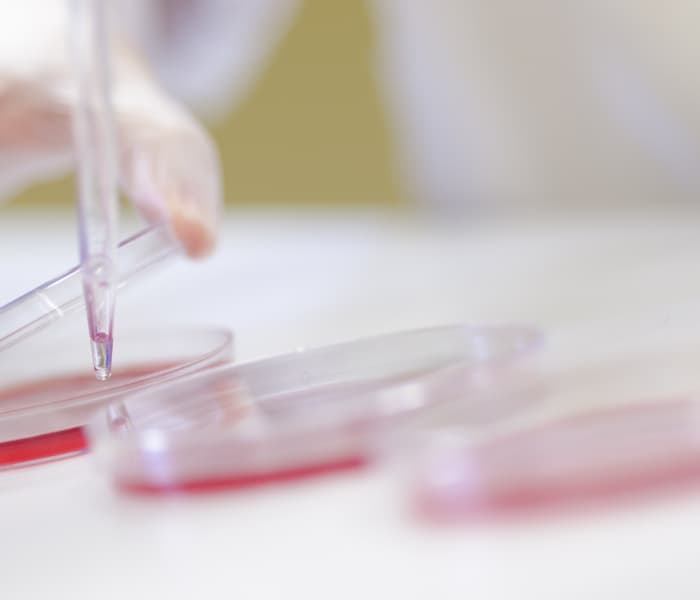
Investigación

Nuestro mejor producto, nuestro servicio
Nuestro principal objetivo es facilitar y mejorar el día a día de los profesionales veterinarios y ganaderos. Es por ello que gracias a la cualificación de los profesionales que componen nuestro equipo humano, ofrecemos desde asesoramiento, hasta análisis e investigación.
Auditoría y asesoría
- Detectamos los puntos críticos a través de un profundo cuestionario que abarca todos los aspectos del funcionamiento del centro de inseminación o de la granja
- Instalaciones (situación genográfica, bioseguridad)
- Animales (raza, genética, aspectos sanitarios, enfermedades)
- Proveedores (pienso, genética, etc)
- Nutrición (composición de la ración, toxinas, micronutrientes)
- Sanidad (vacunaciones, serologías, PCR, lazareto, etc)
- Proceso productivo (extracción seminal hasta conservación y envío de dosis en el centro, desde la inseminación al destete en la granja) verificación y calibración de aparatos
- Limpieza y desinfección
- Gestión técnico-económica
- Manejo de recursos humanos
- Prevención de riesgos laborales
- Realizamos una visita de auditoría
- Elaboramos un informe de auditoría con el análisis de situación y las acciones de mejora que pueden implementarse


Análisis y laboratorio
- Motilidad, concentración y cinética espermática mediante análisis automatizado CASA.
- Análisis por citometría de flujo.
- Integridad de membrana plasmática y acrosómica.
- Test funcionales: test de endósmosis, estado de capacitación, etc.
- Microbiología.
- Integridad del ADN espermático.
- Test de toxicidad espermática.
- Identidad genética de dosis seminales y test de paternidad.
- Analizar con más frecuencia verracos con calidad seminal comprometida. Para ello, realizamos un análisis semanal al 5% de los verracos consiguiendo que cada uno de ellos haya sido analizado un total de 2,4 veces al año.)
- Enviar dosis del principio y final de la producción, como método de control de calidad del producto.
- Establecer verracos centinelas.
Investigación
Estamos desarrollando un nuevo programa de análisis de la imagen ecográfica del parénquima testicular, ECOTEXT. El programa se ha verificado y calibrado para su uso con un equipo ecográfico de alta resolución. El software ECOTEXT proporcionará un informe de diagnóstico para cada macho reproductor, con la cuantificación del estado de su parénquima testicular y de otras estructuras anexas.
También participamos en colaboración con la empresa IMV Technologies, en la validación de CoolPigXcell, el nuevo medio diluyente porcino para conservar el semen a 4° C libre de antibióticos y Bactibag, un nuevo envase para dosis seminales porcinas con propiedades bacteriostáticas.

¿Necesitas más información sobre un servicio?
Rellena este breve formulario con tus datos y nos pondremos en contacto contigo lo antes posible